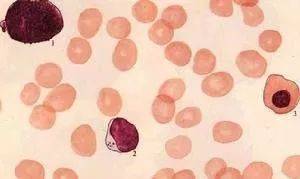
1544408131938557.jpg 微信图片_20181210101456.jpg

这5种食物可以提升白细胞,肿瘤患者收好了!
癌症患者因为治疗原因或者自身免疫力低下经常出现白细胞偏低的情况,正常白细胞数为(4~10)×109/升,通俗说就是每立方毫米4000~10000个,平均值则为7000个。
如果介于4000~7000表示正常偏低,不需治疗;如果低于4000个,就可诊断为白细胞减少症。
即使如此,也不一定就需要治疗,比如说,仅仅是轻度减少或一过性减少,复查时未继续下降,又毫无症状或不适,那就不必紧张,也无需治疗。当然,下列情况下的白细胞需要关注,并在医生指导下,采取干预措施。
1白细胞数严重减少需要紧急治疗
白细胞是由粒细胞、淋巴细胞、单核细胞等组成。一般所说的白细胞减少最常见最主要的是指粒细胞减少,如果减少程度过于明显,则细菌很可能在机体完全或基本丧失抵抗力的状态下迅速扩散,甚至进入血液引发败血症,严重威胁生命。
2有原因可寻的白细胞减少应针对原因治疗
常见引起白细胞减少的原因一般有三类:
一是药物,如服用解热镇痛药、磺胺类药等,此时如白细胞减少过于明显,则应停服或换药。
二是病毒感染,如流行性感冒、病毒性感染等,此时一方面应积极进行抗病毒治疗,另方面可酌情服用增加白细胞的药物。
三是患有免疫系统疾病,如类风湿性关节炎等,此时也应做同样干预,选服能增加白细胞的药物。
3同时有红细胞和(或)血小板减少时需要进一步诊治
当出现白细胞减少时,如果血液中其他两种细胞即红细胞和血小板有异常变化,问题就比较复杂,首先要进一步检查,最常做的是骨髓检查,以排除有无其他血液病,然后再决定治疗方案。

白细胞减少除了正常的治疗外,食疗也不可忽视。下面,为你推荐一些增加白细胞的食物。常见的增加白细胞的食物,一起来看看。
1大枣
大枣有补脾、益气、养血的功效,凡血虚、贫血、血小板减少、白细胞减少者,均宜食用。对肿瘤病人经放疗或化疗后引起白细胞减少者,民间习惯用红枣同赤小豆、糯米煮粥服食。
2香菇
据报道,从鲜香菇中提取的多糖类,对白细胞减少症有明显疗效。一般家庭可用鲜香菇适量煮食或做菜常食。香菇还有提高自身免疫功能的作用,可以用来增强恶性肿瘤病人化疗、放疗的效果,预防由此所致的白细胞下降等免疫功能低下症。

3人参
人参能大补元气、强壮身体,对表现为气虚及阳气不足、体虚气短、怕冷乏力的白细胞减少症患者尤为适宜。
4花生米
花生米有“长生果”的美誉,是家庭日常待客的果品之一,它营养丰富,药用价值也不容忽视。最新实验研究表明,食用花生能增加白细胞,尤其是对肿瘤病人因放疗、化疗引起的白细胞减少症有明显的疗效。

5枸杞
继发性白细胞减少症状明显,病因清楚者要在医生指导下采取药物治疗,而原因不明的轻微白细胞减少可采取食疗。其中枸杞精枣汤效果不错。材料及服用方法为枸杞子9克,黄精、大枣各30克,水煎服,每日1剂,分2次服。
白细胞减少患者应忌食生萝卜、苦瓜、金橘等耗气伤正之品;也忌食胡椒、辣椒、桂皮等辛辣温燥伤阴的刺激性食物;还忌食生瓜、茼蒿、香蕉、螃蟹、蚌肉、田螺等寒凉损阳、生冷伤脾食品。
收藏
回复(13)参与评论
评论列表
 开心快乐291
开心快乐291























